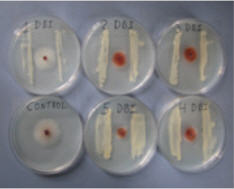

|
E
l hongo Fusarium oxysporum es un habitante común y diverso del suelo. Este género de hongos incluye un número relevante de especies de hongos patógenos que afectan negativamente a cultivos de importancia económica a nivel mundial. Sin embargo, la mayoría de las cepas de F. oxysporum son saprófitos y normalmente son aislados de tejidos vegetales internos después de haber pasado por un proceso de desinfección superficial de las diferentes partes de las plantas (raíz, tallos y hojas). Las cepas de Fusarium no patogénicas son importantes en la producción de cultivos, ya que algunos de ellos han mostrado un efecto de inducción de resistencia en plantas colonizadas (Alabouvette, Schippers, Lemanceau, y Bakker, 1998; Larkin y Fravel, 1999; Pereira, Vieira, y Azevedo, 1999; Trouvelot, Olivain, Recorbet, Migheli, y Alabouvette, 2002; Sikora, Schaefer, y Dababat, 2007).
Las bacterias endofíticas son aisladas de los tejidos
vegetales internos, a través de un proceso de desinfección
superficial de diferentes partes de las plantas (raíz, tallo y
hojas). No obstante, este tipo de bacterias tienen la habilidad
de colonizar también la superficie de los tejidos vegetales
(Hallman, Quadt-Hallmann, Miller, Sikora, y Lindow,
2001). El potencial de este tipo de microorganismos ha sido
demostrado a través de varios estudios (Sturz, Christie, y
Nowk, 2000; El-Batanony et al., 2007; Sikora et al., 2007), ya
que inoculaciones de varios tipos de cepas de Rhizobacterias
en diferentes cultivos resultó en la disminución de la
agresividad de varias enfermedades causadas por patógenos
del suelo.
La variabilidad en el nivel de control biológico
de las plagas y enfermedades, asociadas a la aplicación
de microorganismos endofíticos, es considerado como
un factor limitante al usar agentes antagonistas para la
protección de cultivos. La variabilidad en el nivel de control,
se debe probablemente a que este tipo de estrategias se
basan normalmente en la aplicación de un solo tipo de
microorganismo. En estos casos, el control se limita a un
período corto de tiempo como resultado de fluctuaciones
bióticas y abióticas en el suelo (Dunne et al., 1998; Reimann,
Hauschild, Hildebrandt, y Sikora, 2008). En consecuencia, el
diseño de estrategias que involucren la aplicación simultanea
de microorganismos benéficos han sido sugeridas como una
medida para mejorar el nivel de control biológico (Dunne
et al., 1998; El-Tarabily et al., 2000; Chaves, Pocasangre,
Elango, Rosales, y Sikora, 2009).
Las asociaciones de diferentes tipos de
microorganismos benéficos probablemente provean distintos
mecanismos o combinación de mecanismos conducentes al
control de diferentes plagas y enfermedades. Por ejemplo,
inhibición de patógenos vía antibiosis, producción de
metabolitos tipo sideróforos, competencia por nutrientes y/o espacio, inducción de resistencia, degradación o inhibición
de la germinación del patógeno, reducción de factores de
patogenicidad y promoción de crecimiento de las plantas por
medio de la producción de fitohormonas (Deshwal, Dubey, y
Maheshwari, 2003; El-Mehalawy, 2004; Sikora et al., 2007).
La interacción directa o indirecta de aplicaciones
simultaneas de endofíticos, debe analizarse al implementar
este tipo de estrategias de control, ya que aplicaciones de
Tricoderma harzianum y micorrizas arbusculares resultó
en inhibición del desarrollo y colonización radicular de
las micorrizas (Wyss, Boller, y Wiemken, 1992). En otro
experimento la colonización de la micorriza se vio favorecida
en presencia de otra cepa de T. harzianum (Filion, St-Arnaud,
y Fortin, 1999). Estudios adicionales, demostraron que al
realizar aplicaciones combinadas de Glomus intraradices y Rhizobium etli G12 para el control de Meloidogyne incognita resultó en un efecto de control aditivo (Reimann et al., 2008);
igualmente, aplicaciones simultaneas de F. oxysporum y
Bacillus firmus causaron una reducción significativa de la
cantidad de Radopholus similis que lograron penetrar las
raíces de banano (Mendoza y Sikora, 2009). No obstante,
la inoculación simultanea de los endofíticos F. oxysporum y Paecilomyces lilacinus no resultó en un nivel de control
aditivo del nematodo R. similis en el cultivo de banano
(Mendoza y Sikora, 2009). La combinación de F. oxysporum Fo162 y R. etli G12 mostró niveles similares de control (en
comparación a aplicaciones individuales) de M. incognita y Aphis gossypii en tomate (Solanum lycopersicum L.) y
zucchini (Cucurbita pepo L.) (Martinuz y Sikora, 2010).
Lo anterior parece indicar que la competencia entre
microorganismos antagonistas, tanto dentro como sobre las
raíces, conduce a la exclusión competitiva y por lo tanto a
la reducción de la colonización y/o actividad de uno o más
de los microorganismos que están siendo usados como
agentes de control biológico. En este contexto, el objetivo
de esta investigación fue evaluar la interacción entre los
microorganismos endofíticos F. oxysporum Fo162 y R. etli
G12 al aplicarlos simultáneamente en experimentos in vitro e
in vivo.
MATERIALES Y MÉTODOS
Plantas. Para todos los experimentos se utilizaron plantas de
tomate (cv. Moneymaker). Las semillas fueron esterilizadas
sumergiéndolas durante un minuto en una solución de etanol
al 75% y luego por tres minutos en una solución de hipoclorito
de sodio (NaOCl). Luego las semillas fueron enjuagadas con
agua esterilizada. Las semillas estériles fueron sembradas en
bandejas múltiples (35 plantas) conteniendo arena esterilizada
con autoclave a 121°C por una hora y aireadas durante dos
días antes de su uso. Las bandejas de siembra se mantuvieron
en una cámara de crecimiento a 25±3°C, 16 h de luz día-1,
60-70% de humedad y fertilizadas semanalmente con cinco
ml de un fertilizante comercial (14-10-14, 2 g l-1). Después de cuatro semanas, las plántulas fueron trasplantadas a maseteros
plásticos de 11 cm conteniendo 300 g de substrato esterilizado
(mezcla de arena-suelo en proporción dos:uno vol:vol) y
transferidas a un invernadero a 27±3°C y 16 h de luz día-1.
F. oxysporum cepa Fo162.
El hongo endofítico F.
oxysporum cepa Fo162, subsecuentemente referido como
Fo162, fue aislado originalmente de los tejidos radiculares
de plantas de tomate cultivar Moneymaker en Kenia y
conservado a -80°C, usando el sistema de preservación de
esporas de microorganismos Cryobank, Mast Group Ltd.,
Merseyside, UK. El inóculo fue producido transfiriendo un
pellet congelado, del sistema antes referido, a platos Petri (90
mm de diámetro) con agar de papa dextrosa (PDA; Difco,
Sparks, MD) suplementados con 150 mg l-1 de sulfato de
estreptomicina y cloranfenicol para evitar el crecimiento de
Figura 1. Diagrama de flujo usado para evaluar la interacción in
vitro de G12 en el crecimiento de Fo162. Modificado de Reimann
(2005).
Experimento 2. Efecto del tiempo de incubación
bacteriano. La cantidad de compuestos antimicrobianos que
producen las bacterias en medios de cultivo, se ve influenciada
por el tiempo de fermentación o crecimiento bacteriano en
dicho medio de cultivo. Para evaluar este factor se utilizó
un sistema de cultivo dual en platos Petri de nueve mm de
diámetro conteniendo 25 ml de APD, la bacteria fue colocada
sobre el medio de cultivo en dos barras paralelas en cada plato
Petri. Cada barra fue colocada a dos cm del centro del plato
bacterias. Luego el cultivo de Fo162 fue incubado por tres
semanas a 25°C en la oscuridad. Los micelios y conidios
fueron raspados de la superficie del agar con una espátula y
suspendidos en agua esterilizada (autoclave a 121°C por 20
min). Las esporas fueron separadas del micelio colando la
suspensión a través de cuatro capas de papel filtro fino. La
concentración de las esporas fue determinada a través de un
hemocitómetro (Thomas Scientific, Philadelphia, PA) y fue
ajustada con agua estéril a 1x106 esporas g-1 de suelo.
R. etli cepa G12. La bacteria endofítica R. etli cepa G12, subsecuentemente referida como G12, fue aislada originalmente de la rizósfera de plantas de papa e inicialmente identificada como Agrobacterium radiobacter, pero reclasificada posteriormente como R. etli (Hasky-Günther, Hoffmann-Hergarten, y Sikora, 1998). La bacteria fue conservada a -80°C usando el sistema de preservación de esporas de microorganismos Cryobank, Mast Group Ltd., Merseyside, UK. Para la producción del inóculo, un pellet congelado conteniendo G12 fue cultivado en platos Petri (90 mm de diámetro) conteniendo agar solido King B durante 36 h a 28°C en la oscuridad (King, Warth, y Raney, 1954). Con este cultivo de bacterias se inoculó un Erlenmeyer conteniendo 100 ml de medio liquido de King B y cultivado durante 36 h a 28°C en un agitador a 100 rpm en la oscuridad. Luego la suspensión de bacterias fue centrifugada a 5 000 x g por 20 min a 10°C. Los pellets resultantes fueron suspendidos nuevamente en una solución de Ringer al 0.25 (Merck, Darmstadt, Germany) y la densidad óptica de las bacterias fue ajustada a dos a una longitud de onda de 560 nm, representando aproximadamente 1.2 x 1010 unidades formadoras de colonia (UFC) ml-1 (Hasky-Günther et al., 1998; Reitz et al., 2000; Reimann et al., 2008).
Evaluación de la interacción in vitro entre Fo162 y G12. Para evaluar la interacción in vitro entre los microorganismos endofíticos se realizaron dos experimentos.
Experimento 1. Interacción en diferentes medios de
cultivo. Para evaluar la interacción entre Fo162 y G12 se
utilizó un sistema de cultivo dual en platos Petri de nueve
mm de diámetro conteniendo diferentes tipos de medios de
cultivos. Para ello, cada plato Petri fue llenado con 25 ml
de uno de los siguientes medios de cultivo: i) Agar de Papa
Dextrosa(APD), ii) Agar Sabouraud Dextrosa (ASD), iii)
Agar de Soya Triptona (AST) y iv) Agar de Tejido de Raíces
(ATR). Los medios APD, ASD y AST fueron preparados
según las instrucciones del fabricante. Para preparar el
medio ATR se utilizó 30 g de tejidos de raíces frescas de
plantas de tomate de cuatro semanas de edad. Las raíces
fueron maceradas y mezcladas con 500 ml de agua destilada
conteniendo 18 g de agar. La mezcla fue calibrada a un litro y
esterilizada en la autoclave a 121°C por 20 min. El bioensayo
fue desarrollado de forma separada en cada uno de los medios
de cultivo antes descritos. Para el experimento la bacteria fue
colocada sobre el medio de cultivo en dos barras paralelas en
cada plato Petri. Cada barra fue colocada a dos cm del centro
del plato Petri y el control no fue inoculado con la bacteria
(Figura 1). Posteriormente, la bacteria fue incubada por tres
días (d) a 28°C en la oscuridad, inmediatamente después una
sección de cinco mm de diámetro de APD con el hongo fue
colocada en el centro de cada plato Petri (Figura 1) e incubado
por un período de tres a cinco d a 28°C en la oscuridad. Cada
tratamiento tuvo 10 repeticiones y el bioensayo fue replicado
dos veces. El efecto de la bacteria sobre el desarrollo del
hongo fue evaluado midiendo el crecimiento radial del
micelio del hongo.
|
|
Resultados de estudios previos relacionados a esta
investigación (Martinuz, Schouten, Menjivar, y Sikora, 2012;
Martinuz, Schouten, y Sikora, 2012; Martinuz, Schouten,
y Sikora, 2013), indicaron que aplicaciones individuales
y combinadas de Fo162 y G12 inducen la resistencia
de las plantas a M. incognita en el sistema radicular y a
Aphis gossypii en las hojas. Sin embargo, las aplicaciones
combinadas de los microorganismos endofíticos no mostró
niveles de control aditivos o sinérgicos del nematodo y el
áfido. Existen evidencias de que la aplicación conjunta de
dos antagonistas, con diferentes mecanismos de acción
y nichos de colonización en la raíz, podría incrementar
la eficacia de la supresión del nivel de infección de los
nematodos (Reimann et al., 2008; Chaves et al., 2009). Por
el contrario, algunos autores han reportado efectos de control
de nematodos no aditivos al realizar aplicaciones combinadas
de bacterias y hongos (Castillo et al., 2006; Mendoza y
Sikora, 2009). A pesar de que el rol de microorganismos
endofíticos específicos, especialmente hongos y bacterias, en
el control de infecciones de insectos y nematodos han sido
bien estudiados (Clay, 1989; Breen, 1994; Saikkonen, Faeth,
Helander, y Sullivan, 1998; Azevedo, Maccheroni, Pereira, de Araújo, 2000; Sikora et al., 2007; Sikora, zum Felde,
Mendoza, Menjivar, y Pocasangre, 2010), poco se sabe sobre
el control biológico de plagas y enfermedades a través de la
aplicación conjunta de diferentes tipos de microorganismos
endofíticos (Gaylord, Preszler, y Boecklen, 1996; Diedhiou,
Hallmann, Oerke, y Dehne, 2003; Martinuz y Sikora, 2010).
Los experimentos in vitro e in vivo desarrollados en esta
investigación fueron diseñados para analizar la interacción
entre dos microorganismos benéficos que fueron aplicados
al mismo tiempo en plantas de tomate.
Los experimentos de antibiosis desarrollados en esta
investigación, resultaron en la reducción del crecimiento
radial de Fo162 en presencia de G12. Esta reducción tuvo
una correlación positiva con el tiempo de incubación de
G12 (en un medio de cultivo sólido). Resultados similares
fueron reportados por El-Botanony, Massoud, Mazen, y
Monium (2007), quienes estudiaron in vitro e in vivo el
efecto inhibitorio de filtrados de cultivos de Rhizobium spp.
en el desarrollo de enfermedades del suelo, incluyendo F.
oxysporum. Ellos encontraron que el efecto de inhibición,
expresado como reducción del crecimiento del micelio
del hongo patógeno, incrementa conforme aumenta la
concentración de los filtrados de la bacteria. La conclusión
del estudio fue que la bacteria endofítica analizada, ejerce
un efecto antagonista sobre algunos hondos patógenos del
suelo.
En ésta investigación, el efecto inhibitorio observado
entre G12 sobre Fo162 podría estar relacionado, en parte,
a la acumulación de metabolitos tóxicos producidos por la
bacteria endofítica mientras se reproduce en los exudados
de la planta. La falta de un nivel de control biológico
sinérgico o aditivo, observado en esta investigación, podría
estar relacionado al hecho de que ambos microorganismos
fueron aplicados al mismo tiempo, causando competencia
por espacio y nutrientes. Para evaluar esta hipótesis, se
diseñó un experimento para analizar la influencia de G12 en
la colonización radicular de Fo162. Los resultados de este
experimento mostraron menor porcentaje de colonización de
Fo162 cuando es aplicado en asociación con G12.
La forma en que estos microorganismos endofíticos
colonizan las raíces, podría ser un tema de importancia en
la interacción de ambos. Olivian et al., (2003) estudiaron
la colonización de F. oxysporum cepa Fo47 en raíces de
lino. Reportaron que el hongo colonizó activamente la
superficie de las raíces. Posteriormente, el hongo penetró
las células de la epidermis para colonizar abundantemente
la hipodermis. Por otro lado, Hallmann et al. (2001)
estudiaron la colonización interna y externa de las raíces de
papa y Arabidopsis por parte de G12. El estudio se realizó
a través de un plásmido promotor de trp que provoca una
fluorescencia verde. Encontraron que la bacteria coloniza
toda la superficie de las raíces, pero la colonización se
concentra principalmente en las puntas de la raíz y las
raíces laterales recién formadas. La colonización interna se
concentró particularmente en las células de la epidermis, así
como dentro o cerca del sistema vascular de la raíz. Además,
Diedhiou et al. (2003) co-inocularon Glomus coronatum y
Fo162 en un intento de incrementar el nivel de biocontrol del
nematodo M. incognita. Los autores del estudio, encontraron
que la presencia de Fo162 estimuló la colonización de G.
coronatum y que las raíces ya colonizadas por G. coronatum,
no pudieron ser colonizadas internamente por Fo162.
La resistencia sistémica inducida ha sido reportada
como un mecanismo de control de G12 (Hasky-Günther
et al., 1998). Este tipo de mecanismo puede afectar el
desarrollo de hongos a como fue demostrado por Mwangi,
Hauschild, Mutitu, y Sikora (2002). Por lo tanto, no se puede
excluir la posibilidad de que este mecanismo sea un factor
que afectó la interacción entre Fo162 y G12. Por esta razón,
se diseñó el experimento de raíz dividida para analizar el
efecto sistémico que causa G12 sobre la capacidad del
Fo162 de colonizar el sistema radicular. Los resultados del
experimento mostraron una reducción significativa en el
porcentaje de colonización del Fo162, cuando el “Inductor”
del sistema de raíz divida fue inoculado con G12. Resultados
similares fueron reportados por Liu, Kloepper, y Tuzun
(1995), quienes usaron un sistema de raíces divididas para
estudiar la resistencia sistémica inducida por Pseudomonas
putida y Serratia marcescens hacia Fusarium oxysporum f. sp. cucumerinum. Los autores encontraron, que ambas
bacterias causaron una disminución en el desarrollo de la
enfermedad, así como una reducción en la colonización
de la raíz por parte del patógeno. No obstante, los autores
no pudieron determinar si la resistencia sistémica inducida
estaba relacionada a sustancias translocables inducidas o
producidas por las bacterias.
Por otra parte, Reitz et al. (2000) usando
experimentos de raíz dividida demostraron que
lipopolisacáridos producidos por G12, funcionaron como
un agente estimulador de la resistencia inducida contra
Globodera pallida en plantas de papas (Solanum tuberosum L.). Además, van Peer y Schippers (1992) encontraron que
lipopolisacáridos producidos por Pseudomonas spp no
patogénicas fueron capaces de inducir resistencia sistémica
hacia F. oxysporum f. sp. dianthi en plantas de clavel. Mwangi
et al. (2002) reportaron resistencia sistémica inducida de
Bacillus sphaericus B43 contra el patógeno F. oxysporum f.sp. lycopersici en tomate. Los autores encontraron que la
actividad de la peroxidasa en los tallos de las plantas tratadas
con la bacteria, incrementó significativamente en un período
corto de tiempo, mientras que la actividad de la β-1,3-
glucanasa no fue afectada por la presencia de la bacteria.
|
REFERENCIAS BIBLIOGRÁFICAS
Alabouvette, C., Schippers, B., Lemanceau, P., & Bakker, P.A.H.M. (1998). Biological control of Fusarium Wilts: toward development
of commercial products. In: G.J. Boland; L.D. Kuykendall (eds). Plant-microbe interaction and biological control. Marcel Dekker,
New York, USA. pp 15-36.
Azevedo, J.L., Maccheroni, W., Pereira, J.O., & de Araújo, W.L. (2000). Endophytic microorganisms: a review on insect control and recent advances on tropical plants. Electronic Journal of Biotechnology, 3, 40-65.
Breen, J.P. (1994). Acremonium endophytc interactions with enhanced resistance to insects. Annual Review of Entomology, 39, 401-423.
Castillo, P., Nico, I.A., Azcón-Aguilar, C., Del Río Rincón, C., Calvet, C., & Jiménez-Díaz, R.M. (2006). Protection of olive planting stocks against parasitism of root-knot nematodes by arbuscular mycorrhizal fungi. Plant Pathology, 55, 705-713.
Chaves, N., Pocasangre, L.E., Elango, F., Rosales, F.E., & Sikora, R.A. (2009). Combining endophytic fungi and bacteria for the biocontrol of Radopholus similis (Cobb) Thorne and for effects on plant growth. Scientia Horticulturae, 122, 472-478.
Clay, K. (1989). Clavicipitaceous endophytes of grasses: their potential as biocontrol agents. Mycological Research, 92, 1-12.
Deshwal, V.K., Dubey, R.C., & Maheshwari, D.K. (2003). Isolation of plant growth-promoting strains of Bradyrhizobium (Arachis) sp. with biocontrol potential against Macrophomina phaseolina causing charcoal rot of peanut. Current Science, 84, 443-448.
Diedhiou, P.M., Hallmann, J., Oerke, E.C., & Dehne, H.W. (2003). Effects of arbuscular mycorrhizal fungi and a non-pathogenic Fusarium oxysporum on Meloidogyne incognita infestation of tomato. Mycorrhiza, 13, 199-204.
Dunne, C., Moenne-Loccoz, Y., Mccarthy, J., Higgins, P., Powell, J., Dowling, D.N., & O’gara, F. (1998). Combining proteolytic and phloroglucinol-producing bacteria for improved biocontrol of Pythium-mediated damping-off of sugar beet. Plant Pathology, 47, 299–307.
El-Batanony, N.H., Massoud, O.N., Mazen, M., & El-Monium, A. (2007). The inhibitory effects of cultural filtratesof some wild Rhizobium spp. on some faba bean root rot pathogens and their antimicrobial synergistic effect when combined with Arbuscular mycorrhiza (Am). World Journal of Agricultural sciences, 3, 721-730.
El-Mehalawy, A.A. (2004). The Rhizosphere yeast fungi as biocontrol agents for wilt disease of kidney bean caused by Fusarium oxysporum. International Journal of Agriculture and Biology, 6, 310-316.
El-Tarabily, K.A., Soliman, M.H., Nassar, A.H., Al-Hassani, H.A., Sivasithamparam, K., Mckenna, F., & Hardy, G. (2000). Biological control of Sclerotinia minor using a chitinolytic bacterium and actinomycetes. Plant Pathology, 49, 573-583.
Filion, M., St-Arnaud, M., & Fortin, J.A. (1999). Direct interaction between the arbuscular mycorrhizal fungus Glomus intraradices and different rhizosphere microorganisms. New Phytologist, 141, 525-533.
Gaylord, E.S., Preszler, R.W., & Boecklen, W.J. (1996). Interactions between host plants, endophytic fungi, and a phytophagous insect in an oak (Quercus grisea x Q. gambelii) hybrid zone. Oecologia, 3, 336-342.
Hallmann J., Quadt-Hallmann, A., Rodriguez-Kabana, R., & Kloepper, J.W. (1998). Interactions between Meloidogyne incognita and endophytic bacteria in cotton and cucumber. Soil Biology and Biochemistry, 30, 925–937.
Hallmann, J., Quadt-Hallmann, A., Miller, W.G., Sikora, R.A., & Lindow, S.E. (2001). Endophitic colonization of plants by the biocontrol agent Rhizobium etli G12 in relation to Meloidogyne incognita infection. Phytopathology, 91, 415-422.
Hasky-Günther, K., Hoffmann-Hergarten, S., & Sikora, R.A. (1998). Resistance against the potato cyst nematode Globodera pallida systemically induced by the rhizobacteria Agrobacterium radiobacter (G12) and Bacillus sphaericus (B43). Fundamental and Applied Nematology, 21, 511-517.
King, E.O., Warth, M., & Raney, E.D. (1954). Two simple media for the demonstration of procyanin and fluorescin. Journal of Laboratory and Clinical Medicine, 44, 301–307.
Larkin, R.P., & Fravel, D.R. (1999). Mechanisms of action and dose-response relationships governing biological control of Fusarium wilt of tomato by non-pathogenic Fusarium spp. Phytopathology, 89, 1152-1161.
Liu, L., Kloepper J., & Tuzun, S. (1995). Induction of systemic resistance in cucumber against Fusarium wilt by plant growth-promoting rhizobacteria. Phytopathology, 85, 695–698.
Martinuz, A., & Sikora, R.A. (2010). Biological control of root-knot nematodes and sucking insects by mutualistic endophytes in tomato and squash. Journal of Plant Diseases and Protection, 117, 137 [Abstract].
Martinuz, A., Schouten, A., & Sikora, R.A. (2012). Effectiveness of systemic resistance toward Aphis gossypii (Hom., Aphididae) as induced by combined applications of the endophytes Fusarium oxysporum Fo162 and Rhizobium etli G12. Biological Control, 62, 206-212.
Martinuz, A., Schouten, A., Menjivar, R.D., & Sikora, R.A. (2012). Systemically induced resistance and microbial competitive exclusion: Implications on biological control. Phytopathology, 102, 260-266.
Martinuz, A., Schouten, A., & Sikora, R.A. (2013). Post-infection development of Meloidogyne incognita on tomato treated with the endophytes Fusarium oxysporum strain Fo162 and Rhizobium etli strain G12. BioControl, 58, 95-104.
Mendoza, A.R., & Sikora, R.A. (2009). Biological control of Radopholus similis in banana by combined application of the mutualistic endophyte Fusarium oxysporum strain 162, the egg pathogen Paecilomyces lilacinus strain 251 and the antagonistic bacteria Bacillus firmus. BioControl, 54, 263-272.
Mwangi, M., Hauschild, R., Mutitu, E.W., & Sikora, R.A. (2002). Rhizobacteria induced changes in tomato metabolism and their relationship with induced resistance against Fusarium oxysporum f.sp. lycopersici. Communications in agricultural and applied biological sciences, 67, 145-147.
Olivain C., Trouvelot, S., Binet, M.N., Cordier, C., Pugin, A., & Alabouvette, C. (2003). Colonization of fax roots and early physiological responses of flax cells inoculated with pathogenic and nonpathogenic strains of Fusarium oxysporum. Applied and Environmental Microbiology, 69, 5453-5462.
Pereira, J.O., Vieira, M.L., & Azevedo, J.L. (1999). Endophytic fungi from Musa acuminata and their reintroduction into axenic plants. World Journal of Microbiology & Biotechnology,15, 37-40.
Reimann, S. (2005). The interrelationships between rhizobacteria and arbuscular mycorrhizal fungi and their importance in the integrated management of nematodes and soilborne plant pathogens. Ph.D. thesis, University of Bonn, Germany.
Reimann, S., Hauschild, R., Hildebrandt, U., & Sikora, R.A. (2008). Interrelationship between Rhizobium etli G12 and Glomus intraradices and multitrophic effects in the biological control of the root-knot nematode Meloidogyne incognita on tomato. Journal of Plant Diseases and Protection, 115, 108-113.
Reitz, M., Rudolph, K., Schroeder, I., Hoffmann-Hergarten, S., Hallmann, J., & Sikora, R.A. (2000). Lipopolysaccharides of Rhizobium etli strain G12 act in potato roots as an inducing agent of systemic resistance to infection by the cyst nematode Globodera pallida. Applied and Environmental Microbiology, 66, 3515-3518.
Saikkonen, K., Faeth, S.H., Helander, M., & Sullivan, T.J. (1998). Fungal endophytes: A continuum of interactions with host plants. Annual Review of Ecology and Systematics, 29, 319-343.
Schulz, B., Rommert, A.K. Dammann, U., Aust, H.J., & Strack, D. (1999). The endophyte–host interaction: a balanced antagonism? Mycological Research, 10, 1275-1283.
Sikora, R.A., Schaefer, K., & Dababat, A. (2007). Modes of action associated with microbially induced in planta suppression of plant-parasitic nematodes. Australasian Plant Pathology, 36, 124-134.
Sikora, R.A., zum Felde, A., Mendoza, A., Menjivar, R., & Pocasangre, L. (2010). In planta suppressiveness to nematodes and long term root health stability through biological enhancement – do we need a cocktail? Acta Horticulturae (ISHS), 879, 553-560.
Sturz, A.V., Christie, B.R., & Nowk, J. (2000). Bacterial endophytes potential role in developing sustainable system of crop production plants. Sciences, 19, 1-30.
Trouvelot, S., Olivain, C., Recorbet, G., Migheli, Q., & Alabouvette, C. (2002). Recovery of Fusarium oxysporum Fo47 mutants affected in their antagonistic activity after transposon mutagenesis. Phytopathology, 92, 936-945.
Van Peer, R., & Schippers, B. (1992). Lipopolysaccharides of plant growth promoting Pseudomonas spp. strain WCS417r induce resistance in carnation to Fusarium wilt. Neth. Journal of Plant Pathology, 98, 129-139.
Wyss, P., Boller, T.H., & Wiemken, A. (1992). Testing the effect of biological control agents on the formation of vesicular arbuscular mycorrhiza. Plant Soil, 147, 159-162.
|
 Revista Científica
Revista Científica